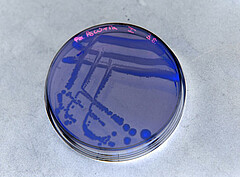

Der mikrobiologische "Fingerabdruck" [28.03.22]
Das menschliche Mikrobiom ist offensichtlich stabiler als gedacht. Das zeigen die Ergebnisse einer Untersuchung, bei der eine neue an der Universität Hohenheim entwickelte bioinformatische Methode zum Einsatz kam. Die Forschenden identifizierten ein „Kern-Mikrobiom“, das in jedem gesunden Menschen über lange Zeit erhalten bleibt und diesen Menschen wie eine Signatur identifizierbar macht. Die Ergebnisse wurden jetzt veröffentlicht (mit Video): DOI: doi.org/10.1186/s40168-022-01251-w
Die Gesamtheit aller Mikroorganismen im und am menschlichen Körper, das Mikrobiom, spielt für dessen Gesundheit eine wesentliche Rolle. Störungen im Ökosystem des menschlichen Darms werden mit vielen Stoffwechsel-, Entzündungs- und Infektionskrankheiten in Verbindung gebracht.
Die genaue Erstellung von sogenannten Mikrobiomprofilen ist wichtig, um ein klares Verständnis von der Rolle des Mikrobioms bei Krankheiten zu erlangen. Die vorhandenen Instrumente können jedoch die verschiedenen Unterarten und Stämme einzelner Bakterien nicht zuverlässig klassifizieren und unterscheiden, was es schwierig macht, Veränderungen in ihrer Zusammensetzung zu erkennen. Doch nur wenn solche Unterschiede und Veränderungen nachvollzogen werden, können für die Krankheit charakteristische Marker identifiziert werden.
Mit Hilfe einer neuen bioinformatischen Methode zur hochauflösenden Analyse von Mikrobiomen, ist es der Arbeitsgruppe von Prof. Dr. W. Florian Fricke jetzt gelungen, sowohl die Beständigkeit als auch die therapeutischen Veränderungen des menschlichen Mikrobioms zu erfassen. Um festzustellen, welche Anteile und Mitglieder der Darmflora sich ständig verändern und welche Anteile konstant bleiben, untersuchten die Forschenden gesunde Menschen über mehrere Monate hinweg mit ihrer Methode.
Dabei identifizierten sie ein „Kern-Mikrobiom“, das in jedem gesunden Menschen über lange Zeit erhalten bleibt und diesen Menschen wie eine Signatur identifizierbar macht. Dabei handelt es sich um viele der gleichen Bakterien, die typischerweise während der natürlichen Geburt von Müttern auf ihre Kinder übertragen werden. Möglicherweise wird dieses individuelle Kern-Mikrobiom deshalb bei Geburt angelegt und prägt den Menschen danach sehr lange, möglicherweise lebenslang.
Die Forschenden untersuchten außerdem, inwieweit sich das Mikrobiom von Patienten verändert, die unter wiederkehrenden Durchfallerkrankungen aufgrund einer Infektion mit dem Keim Clostridioides difficile litten und erfolgreich über eine Stuhltransplantation therapiert wurden. Ihre Ergebnisse zeigen, dass bei einer Stuhltransplantation häufig gerade dieselben Bakterien übertragen werden, die in gesunden Menschen Teil des Kern-Mikrobioms sind.
Wahrscheinlich ist Stuhltransplantation also eine Möglichkeit, auch in erwachsenen Menschen (nach Vorerkrankung und Antibiotikabehandlung) das ansonsten stabile Kernmikrobiom auszutauschen. Andererseits muss aber auch davon ausgegangen werden, dass Patient:innen, die mit einer Stuhltransplantation erfolgreich behandelt wurden, sehr lange Zeit durch das Spendermikrobiom geprägt werden – im positiven wie möglicherweise im negativen Sinne.
Publikation (mit Video)
Podlesny, Daniel; Arze,Cesar; Dörner, Elisabeth; Verma, Sandeep; Dutta, Sudhir; Walter, Jens; Fricke, W. Florian: Metagenomic strain detection with SameStr: identification of a persisting core gut microbiota transferable by fecal transplantation, DOI: 10.1186/s40168-022-01251-w
Kontakt
Prof. Dr. W. Florian Fricke, Universität Hohenheim, Fachgebiet Mikrobiom und Angewandte Bioinformatik, +49 (0)711 459 24841, florian.fricke@uni-hohenheim.de